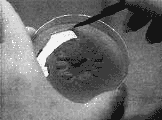

| |
|
Kuzugöbeği
Bu sayfanın çalışmaları devam etmektedir en kısa sürede yayınlanacaktır
Morchella (kuzu göbeği) üretimi için aşağıdaki siteden faydalanabilirsiniz.

Morel photo by Bob Harris
This technique was developed
by mycologist Gary Mills after much trial and error, and observations
of morels growing in nature. What follows is a sequence which
Gary demonstrated for the PBS series, Scientific
American Frontiers. The temperature, humidity, substrate
and other detailed parameters were placed in the public domain
by George Robert Trager.
|
Step 1.

Morels are gathered in the woods. Typically this occurs in the
early Spring. They can be very elusive, but look under the corners
of downed trees, in thick leaves, and in areas recently burned by
forest fire.
Step 2.
Keep the morels fresh as best you can by keeping them in a bag
or box in the field, then refrigerating them when you get home.
Step 3.
In a clean area (preferably under a HEPA hood), use a sterile (heat/alcohol-treated)
paper clip to pierce the stem of a healthy looking mushroom.
Step 4.
Hang the mushroom by the paperclip over a freshly prepared petri dish.
Petris, agar mix and agar preparation instructions can be ordered fromour
agar
page.
Step 5.

Let the morel drip its spores onto the petri plate as you gently work
it with your fingers. If you don't see spores falling, just leave the
mushroom hanging over the agar.
Step 6.

Cover and seal the agar plate and store it (at 55-80°F). You can invert
it to prevent moisture from building up on the lid. After a period of
from a few hours to a few days, the spores will begin to send out their
first mycelial strands into the agar plate
Step 7.

The strands will form a web, and then grow vigorously, extending over
the entire plate. For maintaining rapid growth as we transfer to new
media, the most valuable portion is the outer, leading edge where thin
strands are extending most quickly.
Step 8.
When the plate is fully colonized, you can either transplant sections
into fresh agar, thereby propagating the culture indefinitely, or you
can innoculate grain media with sections of the mycelia you cut from
the plate, using a sterilized (alcohol and heat treated) razor knife.
Resterilize the knife after each transfer.
Step 9.

A good grain medium is annual rye grass seed. Other grains such as
rape seed, hemp seed, birdseed, and rice will work. Cover grain with
water and soak for 24 hours.
Step 10.
Drain and mix with potting soil, 1 part potting soil to 5 parts grain.
Place 2 cups of this medium into a 1 quart regular canning jar. (Sorry,
the pictures are of a pint jar!)
Step 11.

Fit with filter disc and ring and sterilize for 1 hr at 15 psi in an
autoclave.
Step 12.

Clean work surface with 5% bleach, use a laminar flow hood, if possible.
Remove filter disc from jar and quickly add a few small pieces of agar
cultured mycelium with a flame sterilized scalpel. Replace filter disc.
Cover the filter disc loosely with foil to prevent drying of the culture.
Resterilize your scalpel after each transfer.
Step 13.

Shake the jar to thoroughly mix in the mycelium. Place the jar in a
cool (68 - 71°F), dark place for approximately 4 - 6 weeks. Good growth
will be indicated by whitish strands of mycelium growing through the
medium. At about 5 weeks, small aggregates of white to rust colored
mycelia scerotia will form.
Step 14.

After the schlerotia are visible within the jars, prepare some clean
trays to receive the mixture for fruiting. Construct a fruiting room
where temperature, humidity, light and fresh, filtered, air can be precisely
controlled. The Mushroom Cultivator by Stamets and Chilton has excellent
ideas on growing rooms.
Step 15.
Make a fruiting substrate mix of 20% sand, 30% potting soil, 50% organic
material composed of 80% small hardwood chips (ash, oak, maple, beech,
elm, apple, etc.), 10% rice hulls, 5% soybean meal, 5% sphagnum, and
a small amount of lime (the mineral, not the fruit) to bring the pH
to 7.1-7.3. Mix well.
Step 16.

Fill an autoclavable aluminum 9-1/4 X 9-1/4 X 2-1/2 inch tray (i.e.
cake pan) or plastic dishpan (liberally punched with drainage holes)
to a depth of 2 inches with substrate.
Step 17.
Saturate
substrate thoroughly with water. Allow to drain completely. Fill a second,
identical tray with soaked, drained rye grass seed to a depth of 1/2
- 1 inch. Set substrate tray into rye seed tray so that the bottom of
the substrate tray rests on the rye seed. Place the prepared trays inside
an autoclave bag (oven cooking bags seem to work well) fitted with a
filtered closure and sterilize at 15 psi for at least one hour.
Step 18.
In
a clean (use 5% bleach to clean up) draft- free area (laminar flow hood
recommended) open cooled substrate bag and mix ca. 1/2 cup spawn into
substrate using a flame-sterilized spoon. Reclose bag and place in a
cool (65-70°F) dark place for 4-6 weeks. During this period (the spawn
run) the relative humidity should be kept at 90-100%, CO2 at 6000-9000
ppm, and no fresh air exchanges.
Step 19.

After 4-6 weeks, the surface of substrate should be covered with sclerotia.
The hard schlerotia lumps are the secret to growing morels. These are
the "seeds" of your mushrooms. Keep unused spawn refrigerated at 38-40°F.
Spawn is viable for up to a year, under optimal conditions.
Step 20.
CHILLING (a necessary step): After spawn run, remove rye seed tray
from bag, reclose, and place bagged substrate tray into refrigeration
(38-40°F) for two weeks.
Step 21.
Remove bagged tray from refrigeration. Remove substrate tray from bag
and place in fruiting chamber or room. Slowly saturate substrate with
sterile (65-70°F) water at a rate of 1.5-2.5 fluid ounces/hr/square
foot of substrate surface area for 12-16 hours. Allow substrate to drain
completely (for about 24 hours).
Step 22.
CASING (optional): Layer casing soil evenly to a depth of 1/2". Allow
7-10 days for mycelium to run through the casing. Air temp 65 - 70°F.
Filtered fresh air exchanges at 1 - 2 per hour. Keep dark.
Step 23.
Primoridia
will form in 3-7 days. Substrate moisture 60%, relative humidity 95-100%,
air temp 70 - 73°F, filtered fresh air exchanges 6 - 8/hr. Light cycle
12 on / 12 off (grow lights). Keep CO2 less than 900 ppm.
Step 24.
FRUIT BODY MATURATION: Substrate moisture 50%, relative humidity 85-95%,
air temp 73 - 77°F. filtered fresh air exchanges 6 - 8/hr. Light cycle
12 on / 12 off (grow lights). Keep CO2 less than 900 ppm.
Step 25.
You
can also grow outdoors using sawdust spawn available from Mushroompeople.
Plant Spring through Fall. Inoculated area must be kept moist during
hot, dry periods. Plant under the type of trees where you find morels
in your area, i.e. ash, oak, maple, beech, elm, old apple orchards,
etc., in your garden with perrenials such as jeruselum artichoke or
asparagus. HOW TO PLANT: Gently remove forest litter from 7-8 square
foot area for each pound of spawn to be planted. Loosen soil to a depth
of 1 - 2 inches and moisten lightly, if dry. For each 7 - 8 square foot
area, add 1 pound (soaked 48 hours) wood chips (from above types of
trees) to loosened soil. Next, break up spawn and distribute evenly
over prepared areas. Mix lightly with wood chips and soil. Replace litter
and keep moist, especially during hot, dry months. Supposedly, a cover
crop of clover helps to keep soil moist and adds nitrogen to the soil.
WHEN THEY FRUIT: Late April - early June. Fruiting should occur the
spring following planting. If you have a dry spring, be sure to water
the planted area.
Step 26.
Cook 'em up! For a section of excellent cookbooks, visit our on-line
catalog!
The morel life cycle
Thomas J. Volk, Dept. of Biology , 3012 Cowley Hall, University
of Wisconsin- La Crosse, La Crosse WI 54601 mailto:volk.thom@uwlax.edu
Return
to Tom Volk's Fungi Home Page
See also this
page, where the morel was Fungus of the Month.

Modified from an article originally published in McIlvainea 10(1):76-81,
1991. as "Understanding the morel life cycle: Key to cultivation"
The morel, one of the most prized and most delicious mushrooms,
has finally been cultivated. The morel is perhaps the best known
of the edible fungi, since it is easily identified even by those
who have but a slight knowledge of mycology, one of Christiansen's
Infallible Four. Although many "lesser" mushrooms are easily cultivated,
e.g. Agaricus brunnescens (= A. bisporus), Pleurotus
spp., and shiitake, the morel has defied all attempts at consitent
indoor cultivation until very recently.
Here in the Midwest, one of the major pleasures of the spring season
is going out in the woods after the snow melts to see the variety
of ephemeral plants and fungi that are not present at other times
of the year because of shading by large deciduous trees. Almost
as an added bonus, it is possible that if one finds some dead elm
trees, old apple orchards, some black cherry trees, or the results
of a previous year's fire, and if there has been enough rain and
if the temperature is neither to
hot nor too cold and if the winter has been neither too mild nor
too severe, and if one happens to be at the right place at the right
time, one may also find morels. It is not easy to predict in advance
of a hunt whether there will be some morels found in a particular
place, even in a known "morel spot." The thrill of the hunt is precisely
what makes morelling so exciting... and often so frustrating. Nearly
every morel hunter has a ready list of excuses why no morels are
being found: too hot, too cold, not enough rain, too much rain,
not enough humidity, too humid, the tree hasn't been dead long enough,
the tree's been dead too long, the may apples aren't blooming yet,
the oak leaves aren't yet the size of a squirrel's ear, and so on.
The apparent lack of identifiable consistent conditions that lead
to wild morel fruiting has been a major deterrent in establishing
protocols for artificial morel cultivation.
Almost
as if to further confound the facts, morels fruit in the western
United States in a much different manner. They rarely have any relationship
with particular plants or trees, but instead appear most often in
a variety of disturbed habitats, especially after forest fires,
in logging "skid trails," and in horticultural plantings, especially
in "bark dust." A trip in 1991 to the Malheur National Forest in
eastern Oregon revealed morels coming up in places and under conditions
I would not even consider looking in the midwest or east. On the
site of a massive forest fire the previous year, we saw literally
hundreds of morels within a few hundred square feet, and the fire
covered several hundred acres, so one can imagine the large number
of morels during the entire fruiting season. The snow had melted
about three weeks earlier at the site we visited, and, although
the ground appeared to be quite dry, the morels were appearing everywhere,
especially on the sides of the holes created where trees burned
well into the ground. According to area foresters, there had not
been morels on this site in any previous years, probably not since
fires ravaged the area 100 years previously. The ecological aspects
of the situation, e.g. the role of morel mycelium in the healthy
forest, is not yet clear and is often confusing and frustrating
for those of us looking for a consistent pattern.
It
is precisely this frustration and overall lack of knowledge as well
as the general "mystique" that envelopes the morel, that has generated
the excitement of the patenting of a process to grow morels (Morchella
sp.) under controlled conditions (U.S. Patent nos. 4,594,809
and 4,757,640). Most people ask the same few questions: does the
process really work? Is the process repeatable and consistent? Why
are morels so difficult to fruit under controlled conditions? If
mushroom growers can get Agaricus, shiitake and oysters mushrooms
to form, why should the morel be different? The answers to these
questions lie in an understanding of the life cycle of the morel.
Figure 1 is a representation of the mo
Leonard 1990, Volk and Leonard, 1989a). Even a glance at the figure
will reveal a stage of the morel life cycle not present in the other
cultivated mushrooms: the sclerotium. The sclerotium of the morel is
a relatively large structure (1mm -5 cm diameter) composed of large
cells with very thick walls that allow the fungus to survive adverse
natural conditions, such as winter. In the spring, the sclerotium has
two options for germination; to form a new mycelium or to form a fruiting
body. Unfortunately for the potential grower, it is very easy to get
the sclerotia to form a new mycelium but very difficult to force it
to form a fruiting body. Very specific conditions of nutrition, humidity,
carbon dioxide levels and temperature must be met for primordia to form.
Although difficult, however, this part is relatively easy. The primordium
is very prone to abort at this very young stage if not given the proper
set of conditions, which may be very different from those that allowed
their initiation. It is at best a very tricky business.
Attempts have been made for many years to cultivate morels. The high
price that is commanded by these delicacies ($15-$20 per pound at farmers'
markets in Wisconsin--even with a plentiful crop) has tempted many mushroom
growers; the out-of-season price for morels could certainly be much
higher than this. There are scientific reports on success with growing
morels from as early as 1883 (using such things as jerusalem artichokes,
apples, pumpkin and various other substrates), and certainly there must
have been attempts at cultivation long before that. Many people (myself
included) have had success with fruiting morels in their backyards by
simply throwing out the wash water from collected morels into their
compost piles, their lawn, or (in my case) under some volunteer elm
saplings growing up against the house. The following spring, morels
may appear, sometimes in great abundance. There are kits available commercially
that serve the same purpose. Yes they do really work, but backyard success
is often a matter of luck, although there are several tricks that may
be employed (such as "proper" burning, frequent watering, or killing
the elm saplings at the right time of year) to greatly enhance one's
success rate.
Some possible reasons for difficulty in fruiting the morel are made
very clear by examination of the time frame involved with fruiting of
fire-induced western morels. A massive fruiting of morels occurs after
a forest fire. Many spores are released that eventually germinate to
form mycelia and then form sclerotia before the next snow cover. They
do not fruit again, existing in the soil in the form of sclerotia or
cycling between the sclerotial and mycelial stages, until the next forest
fire, on the average 80-100 years later. Given this time frame and our
lack of knowledge concerning the natural role of the morel in this ecosystem,
it is not surprising that artificial cultivation of morels, even outdoors,
is so difficult.
Despite some scattered reports of outdoor cultivation, however, attempts
to control fruiting indoors met with only scattered success until Ronald
Ower of San Francisco succeeded in regularly cultivating morels, publishing
his results in 1982. Naturally, the methods he described in his paper
were quite vague. (After all, if you discovered something that important,
you would want everyone to know about it, but you wouldn't want them
to be able to do it also!) Ower had difficulty convincing any established
mushroom company that he had a process that worked and that the company
would be able to make a profit. At this point the Neogen company of
East Lansing, Michigan became interested in the process. Neogen is affiliated
with Michigan State University and at that time was already the holder
of a number of biotechnology patents. Neogen was able to convince Ower
to come to East Lansing to develop a commercial process for growing
morels. In April of 1986, U.S. Patent no. 4,594,809 was issued. Tragically,
Ron Ower did not live to see the patent granted; he had been murdered
a few weeks before in San Francisco.
The
patents themselves (see also Volk and Leonard, 1989b) describe a process
for formation of sclerotia that are competent to produce fruiting bodies.
Morel sclerotia do not normally form until the nutrients of a substrate
have almost run out. One trick to forming large sclerotia is to inoculate
morel mycelium on a nutrient-poor substrate (such as soil) and allow
it to use its limited nutrient reserves to reach a nearby nutrient-rich
substrate. The nutrients are then translocated back into the old mycelia
where the sclerotia are formed as they begin to store the nutrients
as lipids. These sclerotia can often be quite large and have very much
the same consistency and slippery feel as walnuts. When the sclerotia
are mature, the nutrient source is removed, and water is "percolated"
between the sclerotia in the soil, perhaps simulating spring rains.
After 10-12 days, small primordia appear, and, if the conditions are
correct, the morels mature in 12-15 days. On the surface it seems like
a very simple process, but as with all mushrooms, there are many points
at which the grower can make mistakes and lose the entire crop.
As far as species go, morel taxonomy is a big mess. In the midwest
we have what I (and most people) believe are just three species of morels:
Morchella
esculenta, the gray morel, which is probably the same as M.crassipes,
pictured at the top of this page.
Morchella
conica, the black morel.
Morchella semilibera, the half-free morel.
 I
was very fortunate to visit Meramec State Park in Missouri the weekend
of April 27, 1996 to participate in the Missouri Mycological Society's
MOREL MADNESS foray, at the invitation of Ken Gilberg and Jim Winn.
It was a lot of fun, and I recommend this foray very highly. The picture
is of the morel king (who found 95+ morels) the morel queen (who found
70+ morels), the morel prince (who found the largest morel), and last
year's morel king, holding the 3.75 lb. Gyromitra caroliniana
he found. Most of the morels were found on south slopes, mostly under
recently dead elm trees, but also under living ash and oak trees.
REFERENCES
Leonard, Thomas J. and Thomas J. Volk, 1992. Production of new edible
mushrooms in North America: shiitake and morels. in Frontiers in Industrial
Mycology. Gary F. Leatham editor. Chapman Hall. p. 1-23
Ower, R., 1982. Notes on the development of the morel ascocarp. Mycologia
74: 142-144.
Ower, R., G. Mills, and J. Malachowski, 1986. Cultivation of Morchella.
U.S. Patent No. 4,594,809.
Ower, R., G. Mills, and J. Malachowski, 1988. Cultivation of Morchella.
U.S. Patent No. 4,757,640.
Volk, Thomas J. and Thomas J. Leonard, 1989a. Experimental studies
on the morel. I. Heterokaryon formation between monoascosporous isolates
of Morchella. Mycologia 81: 523-531.
Volk, Thomas J. and Thomas J. Leonard, 1989b. Physiological and environmental
studies of sclerotium formation and maturation in Morchella. Appl. Env.
Microbiol. 55: 3095-3100.
Volk, Thomas J. and Thomas J. Leonard, 1990. Cytology of the Life cycle
of Morchella. Mycological Research 94: 399-406.
This page and other pages are © Copyright 2000 by Thomas J. Volk,
University of Wisconsin-La Crosse.
Return
to Tom Volk's Fungi Home Page
Morel Mushroom Evolution
| |
Growing Morchella.
A Review of Literature to 1996.
|
| |
Home Page
general
Introduction
Summary
Glossary
Explanations
related
Ice Ages
Plants
Find Morels
Links
New
Creationism
Phenotypes
Review
research
Anomaly
Phenotypes
Figures 1-2
Figures 3-6
Figure 7
Figure 8
|
|
 |
|
Not all Morchella research is taken up here, only that portion which is most directly related to growing morels under controlled conditions.
The growing procedure developed by Ronald Ower in 1982 was tried commercially and failed to yield economically practical results. The procedure was cumbersome, requiring sterile conditions and small containers during the early phase, where large masses of sclerotia were produced. And it was unnatural, using sclerotia as a sole source of nutrients for the mycelium. Being abnormal, it was not easily modified or researched.
It also misdirected the science of the subject, as researchers assumed sclerotia was the determining influence over ascocarp formation and the key to solving the mysteries of Morchella.
The patent holders later reported that morels could be produced without sclerotia. Without sclerotia, the theoretical constructions became meaningless.
Nutritional Studies.
A series of nutritional studies based on dry weight measurements were typified by that of Thomas Brock in 1951. He noted that both mycelial growth and sclerotia formation are readily produced on synthetic media.
Pure cultures were started from stipe tissue. A basal medium was used as a derivation of Czapek-Dox medium, consisting of magnesium sulfate, potassium phosphate and ferric sulfate. Carbon was then added, and nitrogen at 250 mg/l.
He first tried measurements of rate of mycelial growth over agar in long tubes, which had been a procedure used in earlier studies. But it did not show as dramatic effects as dry weight with liquid media; so he switched to the later using 125 ml flasks. After six days of growth on liquid media, mycelial mats were removed, dried and weighed.
In comparing carbon sources, he found maximum dry weight from starch, then maltose, d(-)fructose, d(+)turanose, d(+)glucose, sucrose, etc.
With nitrogen sources, the sequence was l-cysteine-HCl, dl-aspartic acid, l(+)asparagine, , urea, etc.
There were numerous limitations to this procedure. Steam sterilization would have resulted in breakdown of many of the media components, as was noted for cysteine-HCl, where H2S gas evolved. Growth on liquid would have been subject to numerous aberrations including a high density mat that forms between the immersed and aerial phases of growth. Inorganic nitrogen would have caused pH extremes to inhibit growth within a few days, but the author did not say what nitrogen source was used with the carbon.
The primary significance of such studies is that dry weight cannot be interpreted in nutritional or physiological terms. The assumption is that a high dry weight measurement indicates a good nutrient. What is a good nutrient, or what is good growth? Rate of growth was not studied, as only one data point was acquired. Implicitly, the starting point was zero, but neither the starting point nor end point would have been in line with the maximum rate, considering that a 1-2 day lag occurs at the start, and adverse effects usually inhibit growth in less that 6 days.
The dry weight produced in 6 days would result from the ability of the mycelium to overcome obstacles to producing cell mass. The primary factors influencing that result would be differentiation, pH extremes, depletion of nutrients, inhibited oxygen diffusion, dehydration of aerial mycelium and strain variations. Those variables cannot be interpreted with the methodology that was used.
Other studies using a similar methodology show widely varying results, which indicates that the conditions had a greater influence than the nutrients being studied.
The "Barrage" or "Meld."
In attempting to control the growth of Morchella mycelium through nutritional and cultural studies, Hervey, Bistis and Leong (1978) encountered an unusual ridge of growth that forms between mycelial types from different spore strains. They called the line of growth a barrage.
They used single spore isolates, combining two per plate, to test compatibility for possible heterothalism. In all non-self combinations, even with spores from the same ascocarp, a build up of aerial growth developed at the line of contact between the colonies.
The authors attempted to explain the phenomenon in terms of usual patterns of fungal life cycles, stating that it indicates "either (1) the ascus fusion nuclei are heterozygous for certain genetic factors, or (2) the asci of a single ascocarp do not all arise from the same pair of nuclei."
They also noticed patterns of variation in mycelial types which they called downy and granular. They then said, "These data again suggest (but do not prove) that heterokaryosis occurs at some time during the life cycle of M. esculenta."
Volk and Leonard (1989) studied the phenomenon further showing that heterokaryotic mycelium forms in the reaction zone between different types of mycelium. They referred to the reaction zone as a meld rather than a barrage, which emphasizes the new type of mycelium which forms. Drug resistant mutants were used to show that the mycelium in the center of the meld contained genes from both strains.
In comparing several thousand spores strains from the same ascocarp, a small percent (less than 3%) did not form a meld. The mycelia grew together with no visible line between them.
Spores from the same asci were evaluated. A pair referred to as sister spores did not result in a meld, while non-sister spores always did.
The Ower Procedure.
In 1982, Ronald Ower published a brief message stating that he had grown M. esculenta under laboratory conditions. He did not describe the procedure, because he wanted to patent it first.
He claimed to have solved the problem of growing morels by determining the life-cycle. The key factor was later revealed to be the production of sclerotia leading to the formation of ascocarps.
Ower's brief note showed photographs of ascocarp development for M. deliciosa, stating that the species is a synonym for M. esculenta. However, the former tends to be smaller. The size is significant, because other evidence indicates that the procedure will not produce a normal morphology for large morels.
A photograph of laboratory grown morels appeared in Discover magazine in May 1988 (Vogel). The image was deliberately out of focus (referred to as silhouetted), but the morphology was very distinctly abnormal. The caps were large and had a smooth surface unlike the sharply defined ridges that normally occur. Considering that the patent holders were trying to put their best foot forward, they must have been unable to produce a normal morphology.
When this author later ordered dried morels from the same company, they were a petite variety of a smaller species, M. angusticeps. The caps had normal ridges, but spores did not produce normal mycelium. Sclerotia was heavily encrusted in the mycelium producing a papery surface. Presumably, petite mutants were used, because the small size facilitated a normal appearing surface structure.
Later, a television program on the laboratory production of morels by the same company showed a tray ofM. angusticeps. Even though the camera angle was very low showing only the tops, there was a visible ball of growth below each morel. Again, the growers were trying to conceal abnormal morphology.
This evidence indicates that the Ower procedure would not produce normal morphology in most instances. The theoretical reason would be that the mycelium normally spreads over a large amount of space in the soil, and when restricted in a tray, it cannot support complete differentiation with large morels. Producing an abnormal morphology would be impossible with other types of mushrooms, but the morel evolved so recently from an ancestor that lacked macromorphology that it does not have strict control over morphology.
A patent based on the Ower procedure was filed in 1986. The procedure involves producing a large amount of sclerotia under axenic conditions using cooked, sterilized wheat in pint jars. Above the wheat is a medium of soil. The depleted nature of the soil causes a large quantity of sclerotia to form, while the mycelium draws nutrients from the wheat below it. Inoculum is described as ascospores, vegative hyphae or sclerotia. Apparently, the pint jars could not be scaled up, because air must enter around the edge and diffuse into the center.
The sclerotia is removed and placed in nonsterile trays with a medium such as soil and peatmoss. Much water is percolated through. Depletion of exogenous nutrients is emphasized as essential to inducing differentiation. Maintaining complex environmental conditions is critical to preventing abortion of growth.
A later patent (1989) described the use of nutrient rich mycelium grown in liquid media as the spawn n place of sclerotia. In other words, sclerotia is not an essential part of production.
Theorized Life-Cycle.
A cytological study was conducted by Volk and Leonard (1990) and used as a basis for a life-cycle theory. They noted that the ascus mother cell contains a large number of nuclei. A pair of nuclei migrate to the tip of the ascus mother cell and fuse to form a diploid nucleus. Then meiosis occurs followed by four successive mitotic divisions creating eight ascospores per ascus. They reported observing eight nuclei per ascospore, presumably resulting from additional mitosis. (The ascospores contain a large and variable number of nuclei for the presumed purpose of increasing the mass to facilitate dissemination as projectiles.)
As they also reported, hyphae contain porate septa. Typically there are 10-15 nuclei per compartment, but sometimes as many as 50. Anastomosis is highly prevalent. Nuclear pairs are sometimes observed in the undifferentiated hyphae.
The authors theorized a life-cycle where plasmogamy between strain variants creates a heterokaryotic mycelium, which they referred to as secondary mycelium. It then is theorized to form heterokaryotic sclerotia which can either revert back to secondary mycelium or lead to ascocarp formation.
The theory was not tested with the Ower procedure to determine whether monoascosporous mycelium (so-called primary mycelium) would produce ascocarps.
The assumption that heterokaryotic mycelium has a role in the life-cycle is contradicted by much evidence. The unusual mycelium taken from the meld was difficult to grow, which is probably why it was not studied more thoroughly. Forming where two types of mycelium come together, nutrients would be depleted in the area limiting its growth potential. If its purpose were to create genetic interaction, a large amount of growth might not be necessary. But the heterokaryotic mycelium is given the role of leading to ascocarp formation, which would require a large amount of nutrients.
Furthermore, such interactions are not usually known to form a barrage or meld. The unusual growth stems from the cells being walled off after they exchange nuclei. Walling off the cells does not promote their growth but robs them of nutrients. This effect and other evidence indicates that the purpose of walling off the cells is to prevent the exchanged nuclei from diluting necessary variations in each spore strain. The spore strains are adaptations to environmental conditions, as studies by this author indicate.
Even with heterokaryosis, the suggested life-cycle is extremely simple. The sexual stage is limited to karyogamy and meiosis occurring in succession within the developing ascus. No mating types are suggested, and all vegetative growth is haploid. Conidia were added to the life-cycle based upon a misinterpreted study of a leaf mold a century ago. The error has not been studied in recent times, and it is discussed elsewhere.
Multiple Alleles.
The question of genotypes was studied through electrophoresis of isozymes by Gessner, Romano and Schultz (1987). They compared two species: M. esculenta and M. deliciosa. Two or three allotypes were found for several genes, and they varied with spore strains from the same ascocarp. There was more variation between species than within species indicating reproductive isolation between the species.
A large number of additional allotype variations were found within the genomes of Morchella in later studies by Yoon, Gessner and Romano (1990); Royse and May (1990); Jung, Gessner, Kuedell and Romano (1993) and Bunyard, Nicholson and Royse (1994).
The results were interpreted by Gessner, Romano and Schultz to mean that "different parental genomes exist in individual offspring from a single ascocarp." The authors suggest that the differences stem from a Mendelian population which segregates allotypes.
There is an unwarranted assumption in that conclusion. It is that differences in allozyme types represent differences in genotypes. Macrogenetics indicates that gene exchange homogenizes the gene pool of local populations. The mechanism involves a loss of half of all genes during recombination. The lost genes reduce variations within an interbreeding group. External sources of variation are required to increase diversity of genomes. These mechanisms eliminate heterokaryosis as a source of diverse genes circulating through the mycelium.
Therefore, such a large number of allotypes cannot represent differences in genotypes. The correct interpretation of the results, particularly when combined with a large amount of additional evidence, is that the differences are phenotypic but not genotypic. This result is similar to embryonic development, where cells which are genotypically identical differentiate into phenotypically different cell types. They do that by turning genes on or off in a manner which is stable through mitosis.
In all of these studies, the authors tried to shoe Morchella into a pattern similar to the fungi which they were familiar with. The pattern did not fit, and the authors often noted the unusual nature of their results. Yet they doggedly persisted in constructing illogical explanations which avoided any indication of Morchella evolving recently from a yeast.
The Future.
Work by this author indicates that controlled growth of morel mushrooms will require liquid nutrients, which of course must be sterilized. Sterilization should be advantageous when mechanized, because it allows greater control and speed of production and eliminates problems with pests. The same technology would have great advantages with Agaricus, because compost could be replaced with liquid nutrients including corn syrup. Such results are readily produced under laboratory conditions.
But unlike Agaricus, Morchella will not grow adequately in batch culture. The primary reason is because Morchella is adapted for spreading, while Agaricus is adapted for clumping. The use of extracellular enzymes to break down solid substrates requires a clumping mycelium, because the enzymes must be concentrated, and the nutrients are concentrated. But Morchella feeds on bacteria which are spread widely through the soil. And Morchella is accustomed to finding a continuous supply of such nutrients.
Therefore, liquid nutrients need to be sprayed over Morchella mycelium on a periodic basis. Between spraying, oxygen must be available, which requires good drainage, because liquids seal out oxygen.
The medium would have to be much more open than usual, because the spreading mycelium of Morchella seals the medium rapidly when using liquid nutrients. The medium might be shredded hardwood or a fibrous material like jute or hemp.
There is an ideal inoculum for the purpose. Morchella forms arthrospores when rich liquid nutrients are combined with high aeration. The arthrospores result from mycelium breaking into small blocks. The mechanism appears to create a method of water-borne dissemination, when mycelium grows to the surface of the soil during heavy rains. A critical characteristic of arthrospores is that they could all be of the same spore strain, which would prevent competition between different spore strains.
The breakdown of mycelium into arthrospores would probably not be a problem when spraying on liquid nutrients. If it is, temporary reduction in aeration might be required.
Induction may require covering the mycelium with a medium. However, a continuum of growth and direct control over differentiation would be preferable. Theory indicates that the mycelium would naturally differentiate when the mass got large and oxygen became restricted below the surface. The patent holders indicated that a depletion of nutrients was required for morel formation, but studies of yeast physiology indicate that only nitrogen needs to restricted to promote differentiation.
References.
Brock, T. D. (1951). Studies on the nutrition of Morchella esculenta Fries. Mycologia 43, 402-422.
Bunyard, B. A., Nicholson, M. S. & Royse, D. J. (1994). A systematic assessment of Morchella using RFLP analysis of the 28S ribosomal RNA gene. Mycologia 86, 762-772.
Gessner, R. V., Romano, M. A. & Schultz, W. R. (1987). Allelic variation and segregation in Morchella deliciosa and M. esculenta. Mycologia 79, 683-687.
Hervey, A., Bistis, G. & Leong, I. (1978). Cultural studies of single ascospore isolates of Morchella esculenta. Mycologia 70, 1269-1274.
Jung, S. W., Gessner, R. V., Kuedell, K. C. & Romano, M. A. (1993). Systematics of Morchella esculentacomplex using enzyme-linked immunosorbent assay. Mycologia 85, 677-684.
Ower, R. (1982). Notes on the development of the morel ascocarp: Morchella esculenta. Mycologia 74, 142-144.
Ower, R. D., Millls, G. L. & Malachowski, J. A. (1986). Cultivation of Morchella. U.S. Patent No. 4,594,809.
Ower, R. D., Millls, G. L. & Malachowski, J. A. (1989). Cultivation of Morchella. U.S. Patent No. 4,866,878.
Royse, D. J. & May, B. (1990). Interspecific allozyme variation among Morchella spp. and its inference for systematics within the genus. Biochemical Systematics and Ecology 18, 475-479.
Vogel, S. (1988). Taming the Wild Morel. Discover, May, 1988, 9, 58-60.
Volk, T. J. & Leonard, T. J. (1989). Experimental studies on the morel, I. Heterokaryon formation between monoascosporous strains of Morchella. Mycologia 81, 523-531.
Volk, T. J. & Leonard, T. J. (1990). Cytology of the life-cycle of Morchella. Mycological Research 94, 399-406.
Yoon, C., Gessner, R. V. & Romano, M. A. (1990). Population genetics and systematics of the Morchella esculenta complex. Mycologia 82, 227-235.
|
|
|